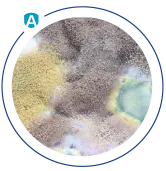
Fungal Spores

Ultimate Defence
Neutralised Allergens
Neutralises allergens commonly found in house dust using a total anti-allergen protection coating which lasts for up to 6 months in a single use.
$0.00 AUD




5.0 / 5.0
(2) 2 total reviews
Allergoff Wash removes common allergens from fabrics including house dust mite allergens, mould, pollen and pet allergens.
Please note, if multiple units are ordered, only one will be dispatched per order.
Couldn't load pickup availability
Allergoff Wash removes common allergens from fabrics including house dust mite allergens, mould, pollen and pet allergens.
Allergoff Wash Laundry Additive facilitates the physical elimination of parasites present in fabrics at temperatures below 60°C including: fleas, ticks, scabies, lice, dust mites, bed bugs, and face mites. Allergoff Wash reduces the risk of transferring ticks into the home environment without the use of pesticides.
Allergoff Wash supports the treatment of inhaled allergy symptoms and infections of face mites (Demodex) and scabies (Sarcoptes scabiei).
Use Allergoff Wash on a range of fabrics including clothes, sheets, blankets, towels, and pet bedding.




Children with the burden of allergy inheritance – protects against first allergy symptoms in infants and children.
Allergy sufferers with first signs of sensitisation – inhibits the development of allergic diseases such as asthma, eczema, and atopic dermatitis
People with developed allergy symptoms – protects against allergy exacerbation and improves quality of life.
Neutralises allergens commonly found in house dust using a total anti-allergen protection coating which lasts for up to 6 months in a single use.

An allergy is the body’s hypersensitivity to contact with allergens, i.e. a substance which causes pathological reaction of the immune system. It may manifest as a food allergy, airborne allergy or contact allergy. Each allergy reaction may result in specific symptoms, such as hay fever, watery eyes or even anaphylactic shock in severe cases. Some allergic diseases may be hereditary and their occurrence is determined by specific groups of genes. But in fact – we do not inherit the allergy itself, but a tendency to become susceptible to an allergen.
Airborne allergens are the most common cause of allergy throughout the world. The environment around us is full of allergenic substances. Contact with them may result in burdensome symptoms for the respiratory tract and skin. The group of allergens which most frequently cause airborne allergy consists of: house dust mites, pollen, pet allergens and fungal spores.
One of the ways of testing to confirm or exclude allergy is a skin prick test performed by an allergist. Purified extracts of allergens are used during the test. Examples include: allergens of house dust mites, animal dander, fungi and pollen. Medical history, which helps to determine the circumstances and exacerbation of allergic symptoms may lead a person to test for allergies, Although sensitisation to household dust occurs year-round, its exacerbation is a diagnostic premise. It manifests in the morning and at night, most often in summer and winter (when homes are heated or air-conditioned). Furthermore, well-being may worsen during cleaning, dusting, or emptying the vacuum cleaner. The condition may improve while away from home. The most common symptoms include runny nose, sore throat, dry paroxysmal cough, along with skin lesions.
Watery secretion, nasal obstruction (experienced as a sense of blocked nose), itching and sneezing appear within a few minutes following contact with an allergen. There is also a risk of acute and chronic sinusitis. Exacerbation of symptoms depends on the individual characteristics of the allergy sufferer as well as the concentration of allergens at home.
Severe cases of chronic allergic rhinitis may lead to sleep disorders and reduced daily physical activity and cause difficulties in concentrating while learning and at work.
In order to alleviate symptoms it is important to remove allergens from the environment. Allergy sufferers limit their contact with allergens by removing carpets, curtains and other items that accumulate dust from their homes. Traditionally, even daily cleaning does not protect allergy sufferers from contact with dust and furthermore, when cleaning, dust particles start to hover in the air which only worsen the condition.
As part of prevention, physicians often order to avoid contact with allergens. Effective preventive measures, which were undertaken early, may help to decrease the incidence of allergy and if symptoms occur, the disease may take mild form.
Reducing the concentration of allergens in households to the safe level may improve well-being and significantly enhance life quality of people allergic to household dust.
We recommend using our Allergoff Spray to protect your home and reduce household allergens.
A year-round presence of sensitisation symptoms due to constant exposure to household allergens is a typical sign of allergic rhinitis. In order to distinguish this type of allergy from a common cold caused by viral infection, attention should be paid to the duration of the symptoms. Viral rhinitis usually lasts for 10 days.
Love them
works well
